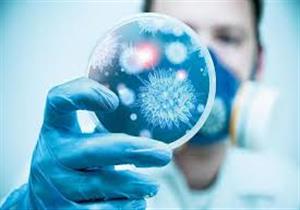
5 خرافات حول أطعمة تعالج المصابين بكورونا.. لا تصدقها

إعلان
-
02 يونيو, 2020
-
14 مايو, 2020
-
28 أبريل, 2020
-
23 أبريل, 2020
-
23 أبريل, 2020
-
20 أبريل, 2020
-
20 أبريل, 2020
-
16 أبريل, 2020
-
16 أبريل, 2020
-
16 أبريل, 2020
-
15 أبريل, 2020
-
15 أبريل, 2020
-
إعلان
-
15 أبريل, 2020
-
15 أبريل, 2020
-
15 أبريل, 2020
-
15 أبريل, 2020
-
14 أبريل, 2020
-
14 أبريل, 2020
-
14 أبريل, 2020
-
13 أبريل, 2020
-
13 أبريل, 2020
-
13 أبريل, 2020
-
12 أبريل, 2020
-
11 أبريل, 2020
إعلان
إعلان